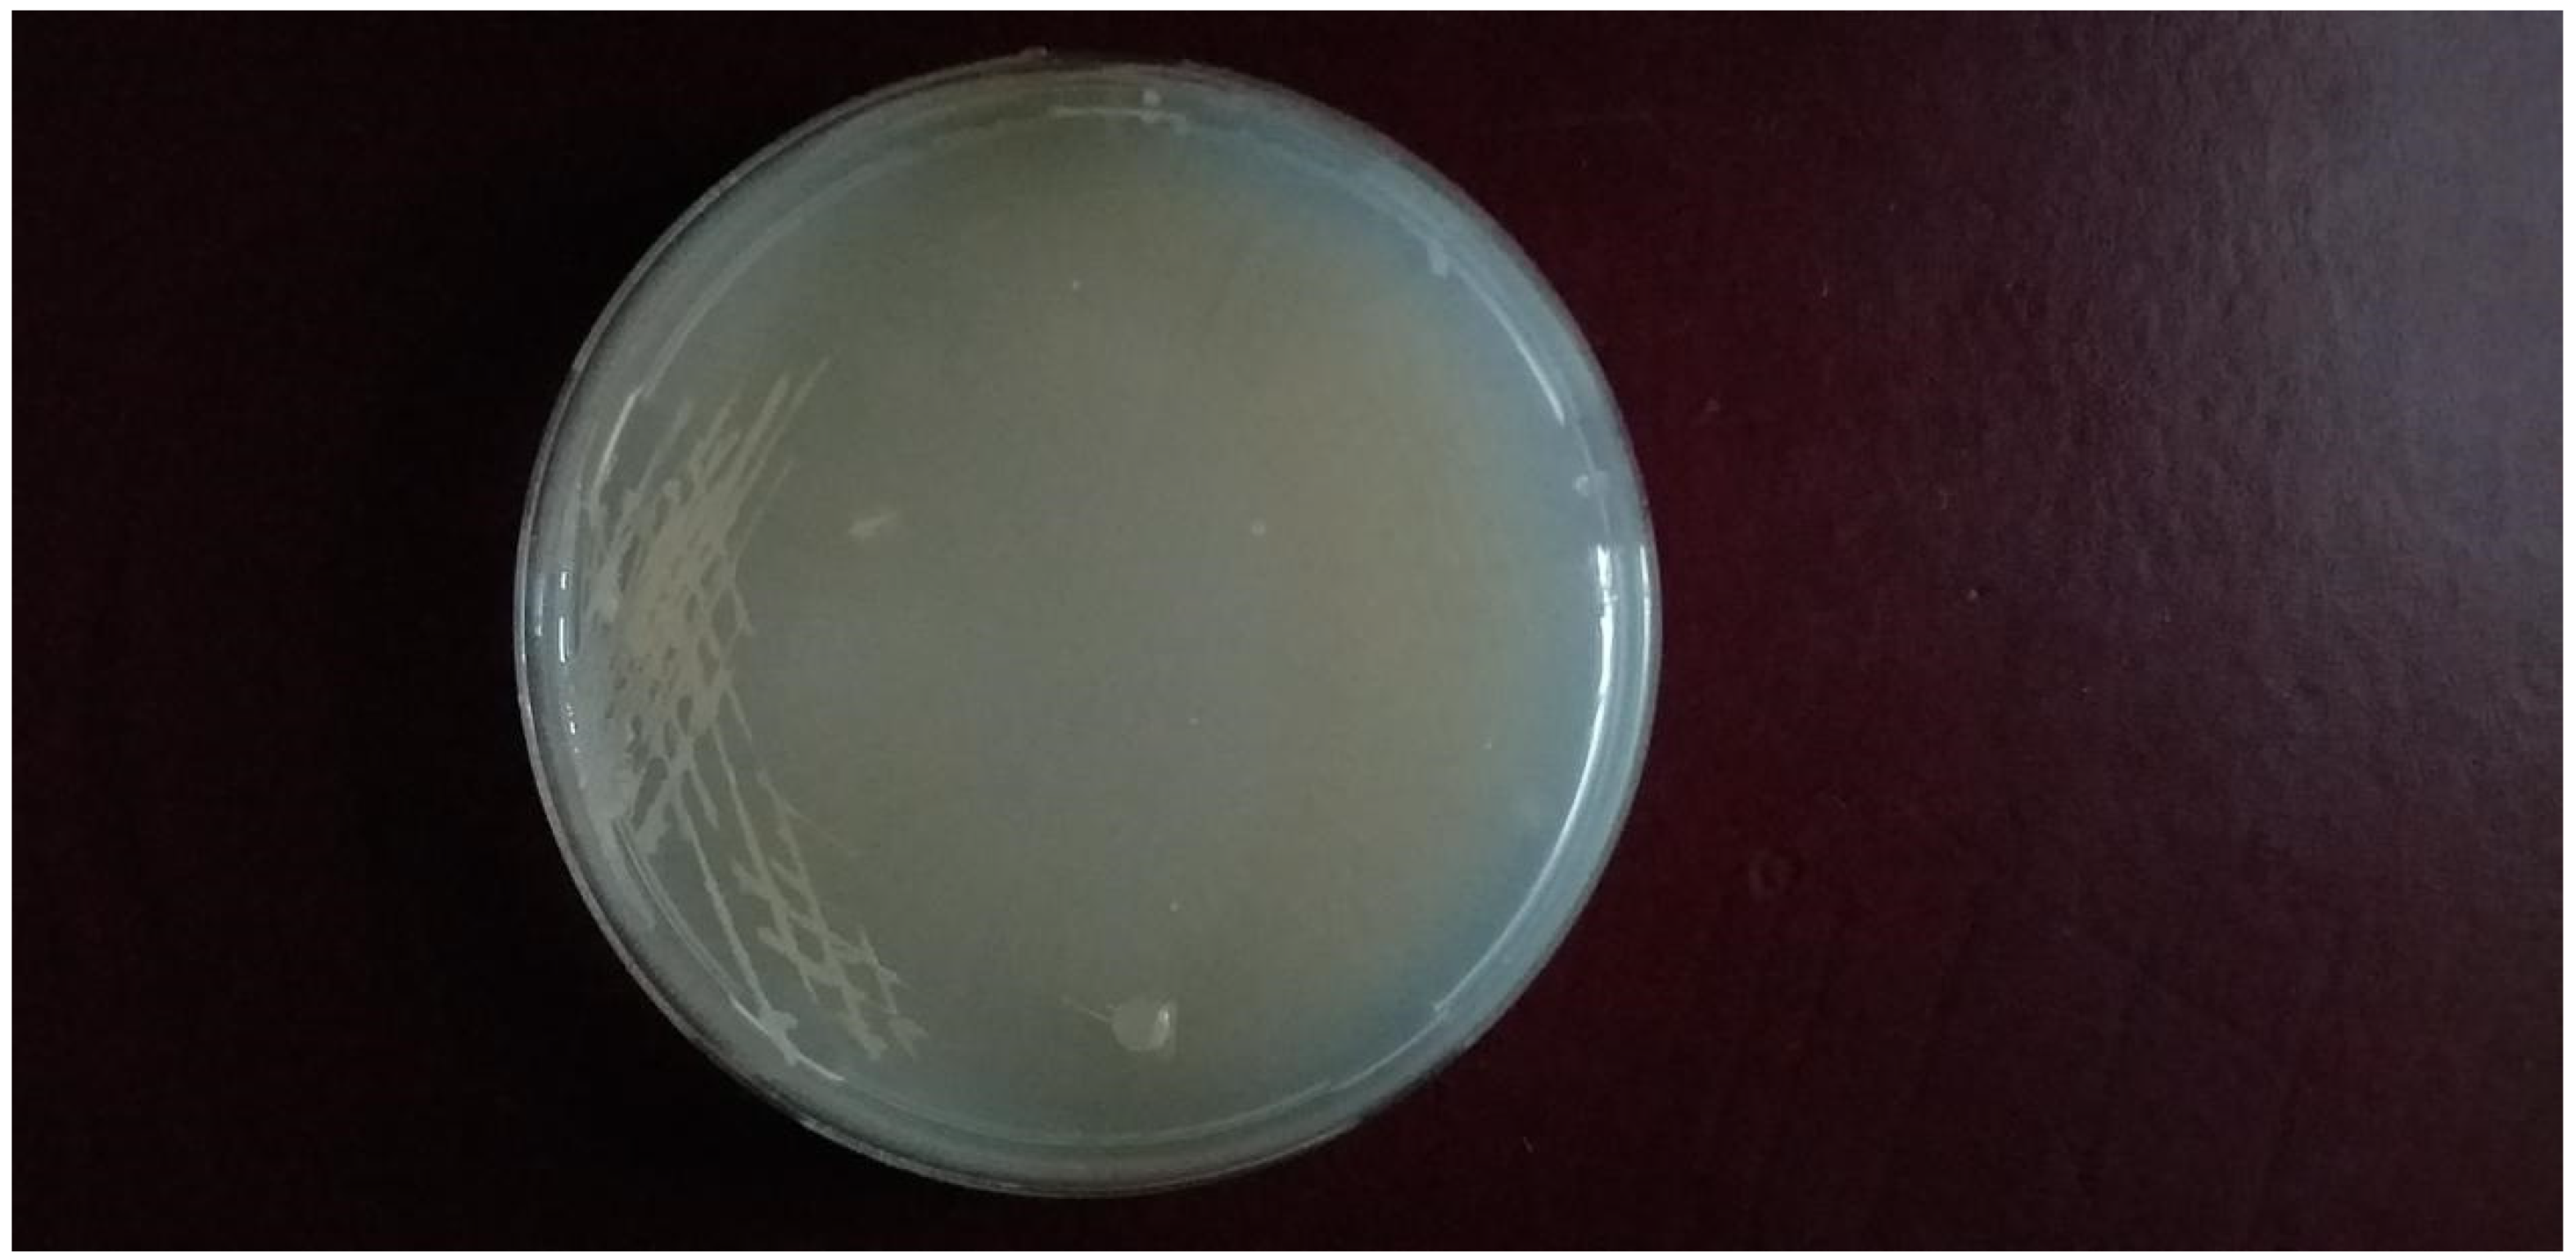
Preprints 106636 g001

Only bacterial isolates which utilized L-glutamine as the sole metabolic source of carbon and nitrogen showed positive growth on selective metallic glutamine agar medium [MGA]. The optimal environmental and physiological factors affecting growth of positive bacterial isolates were PH 7.4 at temperature 37 0C. The morphological and the biochemical tests revealed that Bacillus cereus was the major positive bacterial producing L-glutaminase isolate from the soil samples collected from different soil environments in Egypt. The optimal conditions for characterization of L-glutaminase production were with the following activators KCL, ZnSO4, FeSO4, K2HPO4, MgSO4 at PH 7.4 and temperature 37 0C. L-glutaminase produced from Bacillus cereus showed high efficacy and bio-availability as anticancer agent. Molecular mass of L-glutaminase was approximately 37 KDa, The yield [productivity] was 5.2 U/ml during the initial production from MGA; while it rose to 42.96 U/ml via bacterial recombinant DNA production. L-glutaminase was purified to yield total activity 12,990 ± 19.76 (U), specific activity 384.66 ± 8.92 (U/mg of protein), and purification fold 2 ± 2.99 with final enzyme recovery 55 ± 1.23 %. Furthermore, Mn2+, K+, Na+, and Fe3+ were enzymatic activators that increased the L-glutaminase activity by 19 %, 23 %, 15 %, and 9 %, respectively. It showed potent DPPH scavenging activities with IC50 = 203 μg/mL and anticancer activities against human liver (HepG-2), colon (HCT-116), breast (MCF-7), lung (A-549), lymphocytic (CCL-120) and cervical (Hela) cancer cell lines with IC50 40.72, 9.7, 7.39, 20.61, 51.28 and 11.55 μg/mL, respectively. The kinetic parameters of Km and Vmax were 13.2 × 10-5 M and 119.86 μmol/mL/min, respectively, which reflected a higher affinity for its substrate. The inoculate contained 1*107 spores/ml.
Detection of Immunogenicity of L-Glutaminase Conjugated with PEG
This was accomplished by the use of the ELISA method. During the current investigation, few IgG2 antibodies were detected against L-glutaminase produced by Bacillus cereus.
Table 4 displays the antioxidant activity of standard L-ascorbic acid as measured by the DPPH test. Table 5 displays the antioxidant activity of the test L-glutaminase as measured by the DPPH experiment. The findings of biochemical reactions are shown in Table 27. The influence of substrate concentration on L-glutaminase velocity is shown in Table 26. Table 6 illustrates the cytotoxicity of L-glutaminase on the Hela cervical cancer cell line. Table 7 indicates the detection of L-glutaminase cytotoxicity in the lymphocytic CCL4 cancer cell line. The impact of temperature on the relative activity of L-glutaminase is shown in Table 25. The cellular location of L-glutaminase was determined using the Nesslerization Assay, as shown in Table 23. The impact of PH on L-glutaminase activity is seen in Table 24. The incubation period for L-glutaminase synthesis is shown in Table 20. The growth of L-glutaminase-secreting bacterial isolates on MGA is shown in Table 22. The effect of varied inoculum sizes on L-glutaminase production is shown in Table 21. Table 8 indicates the detection of L-glutaminase cytotoxicity on the A-549 lung cancer cell line. The influence of different Nitrogen sources on L-glutaminase production is shown in Table 17. The influence of static and shaking settings on L-glutaminase production is shown in Table 19. Table 18 indicates the influence of PH on L-glutaminase production. Table 9 indicates the detection of L-glutaminase cytotoxicity on the MCF-7 breast cancer cell line. The cytotoxicity of L-glutaminase on the He-PG-Z hepatic cancer cell line is shown in Table 11. Table 10 indicates the detection of L-glutaminase cytotoxicity on the HCT-116 colon cancer cell line. Figure 1 depicts Bacillus cereus bacterial isolates that were shown to be positive on MGA. The effects of varying NaCl concentrations on L-glutaminase synthesis are shown in Table 16. Figure 6 depicts the 3D structure of L-glutaminase, which has 723 amino acids. The influence of different carbon sources on L-glutaminase production is shown in Table 12. The effect of varied incubation temperatures on L-glutaminase synthesis is shown in Table 14. Graph 1 depicts the antioxidant activity of the test L-glutaminase as measured by the DPPH experiment. The influence of varied incubation conditions on L-glutaminase production is shown in Table 13. Graph 23 depicts the detection of L-glutaminase cellular location using the Nesslerization test. Figure 5 shows the purification of L-glutaminase using a western blot after it was expressed using bacterial recombinant DNA technology. Gram-positive Bacilli-producing L-glutaminase is seen in Figure 2. Figure 4 depicts the plasmid expression vector used to produce L-glutaminase using bacterial recombinant DNA technology. Figure 3 depicts a positive catalase test with Bacillus sp isolates on MGA. Graph 2 depicts the antioxidant activity of standard L-ascorbic acid as measured by the DPPH test. The development of L-glutaminase-secreting bacterial isolates on metallic glutamine agar media is depicted in Graph 22. Graph 20 depicts the influence of temperature on the relative activity of L-glutaminase. Graph 19 depicts the influence of substrate concentration on L-glutaminase velocity. Graph 21 depicts the influence of PH on L-glutaminase activity. Graph 5 depicts the detection of L-glutaminase cytotoxicity on the MCF-7 breast cancer cell line. The cytotoxicity of L-glutaminase on the HePG-Z hepatic cancer cell line is shown in Graph 3. Graph 8 depicts the detection of L-glutaminase cytotoxicity on the Hela cervical cancer cell line. Graph 6 demonstrates the detection of L-glutaminase cytotoxicity on the A-549 lung cancer cell line. Graph 9 depicts the impact of various carbon sources on L-glutaminase production. Graph 11 depicts the influence of various incubation temperatures on L-glutaminase synthesis. Graph 7 depicts the cytotoxicity of L-glutaminase on a lymphocytic CCL4 cancer cell line. The effect of varied inoculum sizes on L-glutaminase production is seen in Graph 18. The influence of static and shaking circumstances on L-glutaminase production is shown in Graph 16. Graph 17 shows the incubation time for L-glutaminase synthesis. The effect of varied incubation conditions [dark and light] on L-glutaminase production is shown in Graph 10. Graph 15 shows the influence of varying PH on L-glutaminase production. The effects of varying NaCl concentrations on L-glutaminase synthesis are depicted in Graph 13. The impact of various metal ions on L-glutaminase cytotoxicity is depicted in Graph 12. The effect of different Nitrogen sources on L-glutaminase synthesis is seen in Graph 14. Table 28 displays the formulation of L-glutaminase as a sterile solution at PH 7.
Figure 1.
It shows positive Bacillus cereus bacterial isolates on MGA.
Figure 1.
It shows positive Bacillus cereus bacterial isolates on MGA.
Figure 2.
Gram positive Bacilli.
Figure 2.
Gram positive Bacilli.
Figure 3.
Positive catalase test with positive bacterial Bacillus sp isolates on MGA.
Figure 3.
Positive catalase test with positive bacterial Bacillus sp isolates on MGA.
Figure 4.
It shows the plasmid expression vector utilized during the expression of L-glutaminase via bacterial recombinant DNA technology.
Figure 4.
It shows the plasmid expression vector utilized during the expression of L-glutaminase via bacterial recombinant DNA technology.
Figure 5.
It displays western blot purification of L-glutaminase after its expression via bacterial recombinant DNA technology.
Figure 5.
It displays western blot purification of L-glutaminase after its expression via bacterial recombinant DNA technology.
Figure 6.
It represents 3D structure of L-glutaminase with 723 amino-acids sequence.
Figure 6.
It represents 3D structure of L-glutaminase with 723 amino-acids sequence.
Graph 1.
Antioxidant activity of test L-glutaminase via DPPH assay.
Graph 1.
Antioxidant activity of test L-glutaminase via DPPH assay.
Graph 2.
Antioxidant activity of standard L-ascorbic acid via DPPH assay.
Graph 2.
Antioxidant activity of standard L-ascorbic acid via DPPH assay.
Graph 3.
Detection of the cytotoxicity of L-glutaminase on HePG-Z hepatic carcinoma cell line.
Graph 3.
Detection of the cytotoxicity of L-glutaminase on HePG-Z hepatic carcinoma cell line.
Graph 4.
Detection of the cytotoxicity of L-glutaminase on HCT-116 colon cancer cell line.
Graph 4.
Detection of the cytotoxicity of L-glutaminase on HCT-116 colon cancer cell line.
Graph 5.
Detection of the cytotoxicity of L-glutaminase on MCF-7 breast cancer cell line.
Graph 5.
Detection of the cytotoxicity of L-glutaminase on MCF-7 breast cancer cell line.
Graph 6.
Detection of the cytotoxicity of L-glutaminase on A-549 lung cancer cell line.
Graph 6.
Detection of the cytotoxicity of L-glutaminase on A-549 lung cancer cell line.
Graph 7.
Detection of the cytotoxicity of L-glutaminase on lymphocytic CCL4 cancer cell line.
Graph 7.
Detection of the cytotoxicity of L-glutaminase on lymphocytic CCL4 cancer cell line.
Graph 8.
Detection of the cytotoxicity of L-glutaminase on Hela cervical cancer cell line.
Graph 8.
Detection of the cytotoxicity of L-glutaminase on Hela cervical cancer cell line.
Graph 9.
Effect of different carbon sources on L-glutaminase productivity.
Graph 9.
Effect of different carbon sources on L-glutaminase productivity.
Graph 10.
Effect of different incubation conditions [Dark and light] on L-glutaminase output.
Graph 10.
Effect of different incubation conditions [Dark and light] on L-glutaminase output.
Graph 11.
It displays the effect of different incubation temperatures on L-glutaminase production.
Graph 11.
It displays the effect of different incubation temperatures on L-glutaminase production.
Graph 12.
The effect of different metal ions on L-glutaminase cytotoxixity.
Graph 12.
The effect of different metal ions on L-glutaminase cytotoxixity.
Graph 13.
It shows the effects of different NaCl concentrations on L-glutaminase production.
Graph 13.
It shows the effects of different NaCl concentrations on L-glutaminase production.
Graph 14.
Effect of different Nitrogen sources on L-glutaminase production.
Graph 14.
Effect of different Nitrogen sources on L-glutaminase production.
Graph 15.
It displays Effect of different PH on the the productivity of L-glutaminase.
Graph 15.
It displays Effect of different PH on the the productivity of L-glutaminase.
Graph 16.
Effect of static and shaking conditions on L-glutaminase productivity.
Graph 16.
Effect of static and shaking conditions on L-glutaminase productivity.
Graph 17.
It displays the incubation time for L-glutaminase production.
Graph 17.
It displays the incubation time for L-glutaminase production.
Graph 18.
Effect of different inoculum sizes on L-glutaminase productivity.
Graph 18.
Effect of different inoculum sizes on L-glutaminase productivity.
Graph 19.
Effect of substrate concentration on the velocity of L-glutaminase.
Graph 19.
Effect of substrate concentration on the velocity of L-glutaminase.
Graph 20.
Effect of different temperatures on relative activity of L-glutaminase.
Graph 20.
Effect of different temperatures on relative activity of L-glutaminase.
Graph 21.
Effect of PH on L-glutaminase activity.
Graph 21.
Effect of PH on L-glutaminase activity.
Graph 22.
It shows the growth of L-glutaminase secreting bacterial isolates on metallic glutamine agar medium.
Graph 22.
It shows the growth of L-glutaminase secreting bacterial isolates on metallic glutamine agar medium.
Graph 23.
It displays the cellular position detection of L-glutaminase through Nesslerization assay.
Graph 23.
It displays the cellular position detection of L-glutaminase through Nesslerization assay.
Table 4.
Antioxidant activity of standard L-ascorbic acid via DPPH assay.
Table 4.
Antioxidant activity of standard L-ascorbic acid via DPPH assay.
| Concentration [mg/ ml] |
% of inhibition of oxidization |
| 0.02 |
15 |
| 0.04 |
29 |
| 0.06 |
38 |
| 0.08 |
49 |
| 0.10 |
80 |
Table 5.
Antioxidant activity of test L-glutaminase via DPPH assay.
Table 5.
Antioxidant activity of test L-glutaminase via DPPH assay.
| Concentration [mg/ ml] |
% of inhibition of oxidization |
| 100 |
30 |
| 200 |
60 |
| 300 |
69 |
| 400 |
81 |
Table 6.
Detection of the cytotoxicity of L-glutaminase on Hela cervical cancer cell line.
Table 6.
Detection of the cytotoxicity of L-glutaminase on Hela cervical cancer cell line.
| Concentration [mcg/ml] |
Percentage of viability [%] |
| 0.001 |
92 |
| 0.01 |
83 |
| 0.1 |
77 |
| 1 |
65 |
| 10 |
58 |
| 100 |
51 |
| 1000 |
44 |
| 10000 |
8 |
Table 7.
Detection of the cytotoxicity of L-glutaminase on lymphocytic CCL4 cancer cell line:.
Table 7.
Detection of the cytotoxicity of L-glutaminase on lymphocytic CCL4 cancer cell line:.
| Concentration [mcg/ml] |
Percentage of viability [%] |
| 0.001 |
97 |
| 0.01 |
89 |
| 0.1 |
71 |
| 1 |
63 |
| 10 |
54 |
| 100 |
50 |
| 1000 |
43 |
| 10000 |
18 |
Table 8.
Detection of the cytotoxicity of L-glutaminase on A-549 lung cancer cell line:.
Table 8.
Detection of the cytotoxicity of L-glutaminase on A-549 lung cancer cell line:.
| Concentration [mcg/ml] |
Percentage of viability [%] |
| 0.001 |
89 |
| 0.01 |
84 |
| 0.1 |
70 |
| 1 |
65 |
| 10 |
56 |
| 100 |
53 |
| 1000 |
40 |
| 10000 |
10 |
Table 9.
Detection of the cytotoxicity of L-glutaminase on MCF-7 breast cancer cell line:.
Table 9.
Detection of the cytotoxicity of L-glutaminase on MCF-7 breast cancer cell line:.
| Concentration [mcg/ml] |
Percentage of viability [%] |
| 0.001 |
91 |
| 0.01 |
83 |
| 0.1 |
69 |
| 1 |
63 |
| 10 |
58 |
| 100 |
52 |
| 1000 |
39 |
| 10000 |
14 |
Table 10.
Detection of the cytotoxicity of L-glutaminase on HCT-116 colon cancer cell line:.
Table 10.
Detection of the cytotoxicity of L-glutaminase on HCT-116 colon cancer cell line:.
| Concentration [mcg/ml] |
Percentage of viability [%] |
| 0.001 |
95 |
| 0.01 |
79 |
| 0.1 |
71 |
| 1 |
66 |
| 10 |
60 |
| 100 |
57 |
| 1000 |
49 |
| 10000 |
23 |
Table 11.
Detection of the cytotoxicity of L-glutaminase on He-PG-Z hepatic carcinoma cell line:.
Table 11.
Detection of the cytotoxicity of L-glutaminase on He-PG-Z hepatic carcinoma cell line:.
| Concentration [mcg/ml] |
percentage of viability [%] |
| 0.001 |
96 |
| 0.01 |
82 |
| 0.1 |
70 |
| 1 |
65 |
| 10 |
58 |
| 100 |
40 |
| 1000 |
19 |
| 10000 |
7 |
Table 12.
Effect of different carbon sources on L-glutaminase productivity:.
Table 12.
Effect of different carbon sources on L-glutaminase productivity:.
| Carbon source |
Productivity [U/ml] |
| Mannitol |
40 |
| Sucrose |
21 |
| Galactose |
25 |
| Starch |
10 |
Table 13.
Effect of different incubatin conditions on L-glutaminase output:.
Table 13.
Effect of different incubatin conditions on L-glutaminase output:.
| Incubation condition |
Dark |
Light |
| L-glutaminase productivity [U/ ml] |
6.9 |
4.3 |
Table 14.
It displays the effect of different incubation temperatures on L-glutaminase production:.
Table 14.
It displays the effect of different incubation temperatures on L-glutaminase production:.
| Incubation temperature [℃] |
Productivity [U/ml] |
| 25 |
19 |
| 30 |
25 |
| 40 |
30 |
| 45 |
26 |
| 50 |
14 |
| 55 |
10 |
Table 15.
The effect of different metal ions on L-glutaminase cytotoxixity:.
Table 15.
The effect of different metal ions on L-glutaminase cytotoxixity:.
| Metal ion |
L-glutaminase activity [U/ ml] |
| FeSO4 |
19 |
| MnCl2 |
31 |
| CoCl2 |
21 |
| NiCl2 |
27 |
| NaCl |
55 |
| KCl |
43 |
Table 16.
It shows the effects of different NaCl concentrations on L-glutaminase production:.
Table 16.
It shows the effects of different NaCl concentrations on L-glutaminase production:.
| NaCl concentration [% w/v] |
Productivity [U/ml] |
| 1 |
5 |
| 2 |
20 |
| 3 |
30 |
| 4 |
40 |
| 5 |
36 |
| 6 |
35 |
| 7 |
31 |
| 8 |
30 |
| 9 |
29 |
Table 17.
Effect of different Nitrogen sources on L-glutaminase productivity:.
Table 17.
Effect of different Nitrogen sources on L-glutaminase productivity:.
| Nitrogen source |
Productivity [U/ml] |
| L-glutamine |
70 |
| Peptone |
60 |
| Ammonium sulfate |
41 |
| Na Nitrate |
45 |
Table 18.
Effect of PH on the the productivity of L-glutaminase:.
Table 18.
Effect of PH on the the productivity of L-glutaminase:.
| PH |
Productivity [U/ml] |
| 5 |
4 |
| 6 |
9 |
| 7 |
20 |
| 8 |
30 |
| 8.5 |
41 |
| 9 |
29 |
| 10 |
20 |
| 11 |
13 |
Table 19.
Effect of static and shaking conditions on L-glutaminase productivity:.
Table 19.
Effect of static and shaking conditions on L-glutaminase productivity:.
| Shaking speed [rpm] |
L-glutaminase productivity [U/ ml] |
| 50 |
5 |
| 100 |
4 |
| 150 |
3.5 |
| 200 |
2.7 |
| 300 |
1.8 |
Table 20.
It displays the incubation time for L-glutaminase production:.
Table 20.
It displays the incubation time for L-glutaminase production:.
| Fermentation time(hr) |
L-glutaminase production(U/ml) |
| 6 |
3 |
| 12 |
10 |
| 24 |
21 |
| 36 |
35 |
| 48 |
24 |
| 60 |
19 |
| 72 |
14 |
| 84 |
10 |
| 96 |
7 |
| 108 |
5 |
| 120 |
4 |
Table 21.
Effect of different inoculum sizes on L-glutaminase productivity:.
Table 21.
Effect of different inoculum sizes on L-glutaminase productivity:.
| Inoculum size [Spores/ ml |
L-glutaminase productivity [U/ ml] |
| 1 |
2 |
| 3 |
4 |
| 5 |
7 |
| 7 |
8 |
| 9 |
3 |
| 11 |
2 |
Table 22.
It shows the growth of L-glutaminase secreting bacterial isolates on MGA:.
Table 22.
It shows the growth of L-glutaminase secreting bacterial isolates on MGA:.
| No. of +ve isolates |
No. of negative isolates |
| 31 |
19 |
Table 23.
It displays the cellular position detection of L-gutaminase via Nesslerization Assay:.
Table 23.
It displays the cellular position detection of L-gutaminase via Nesslerization Assay:.
| Cellular proportion |
Percent [%] |
| Extracellular |
71 |
| Surface bound |
18 |
| Intracellular |
11 |
Table 24.
Effect of PH on L-glutaminase activity:.
Table 24.
Effect of PH on L-glutaminase activity:.
| PH |
Relative activity [ %] |
| 5 |
20 |
| 6 |
31 |
| 7 |
70 |
| 8 |
80 |
| 8.5 |
95 |
| 9 |
92 |
| 10 |
90 |
| 11 |
79 |
Table 25.
Effect of temperature on relative activity of L-glutaminase:.
Table 25.
Effect of temperature on relative activity of L-glutaminase:.
| Temperature [℃] |
Relative activity [%] |
| 25 |
38 |
| 30 |
61 |
| 35 |
69 |
| 40 |
73 |
| 45 |
78 |
| 50 |
86 |
| 60 |
93 |
| 70 |
60 |
Table 26.
Effect of substrate concentration on the velocity of L-glutaminase:.
Table 26.
Effect of substrate concentration on the velocity of L-glutaminase:.
| Substrate concentration [M] |
Velocity [U moles/ min] |
| 20 |
0.02 |
| 55 |
0.04 |
| 80 |
0.06 |
| 90 |
0.08 |
| 95 |
0.10 |
Table 27.
The outcomes of biochemical reactions:.
Table 27.
The outcomes of biochemical reactions:.
| Test |
Result |
| Gram stain |
+ |
| Cell shape |
Rod |
| Spore shape |
Ellipsoidal |
| Spore site |
Central |
| Motility |
+ |
| Catalase |
+ |
| Oxidase |
+ |
| Blood haemolysis |
Beta haemolysis |
| Indol |
- |
| Methyl red |
+ |
| Voges-proskauer |
+ |
| Citrate utilization |
+ |
| Starch hydrolysis |
+ |
| Gelatin hydrolysis |
+ |
| Growth at 45 0C |
+ |
| TSI |
+ |
| Tolerance salinity |
| 5% NaCl |
+ |
| 7% NaCl |
+ |
| Saccharide fermentation |
| Glucose |
+ |
| Fructose |
+ |
| Maltose |
+ |
| Sucrose |
+ |
Table 28.
It displays the formulation of L-glutaminase as a sterile solution at PH 7:.
Table 28.
It displays the formulation of L-glutaminase as a sterile solution at PH 7:.
| Ingredient |
concentration |
| L-glutaminase |
10 mg |
| PEG20 |
50 mg |
| Mono-basic sodium phosphate |
USP, 1.5 mg +5% |
| Di-basic sodium phosphate |
USP, 3 mg + 5% |
| Sodium chloride |
USP, 7.5 mg +5% |
| Water for injection |
Query size to 1 ml |